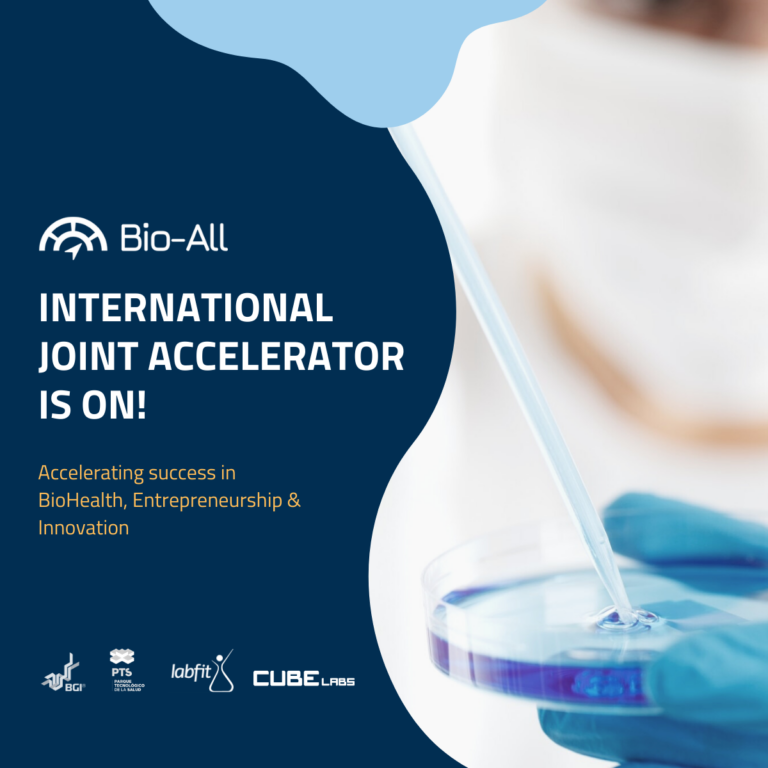

Noticias

Granada Salud avanza en su nueva web y avanza en la organización de nuevos eventos colaborativos
Granada, 14/04/26. Granada Salud continúa reforzando su posicionamiento como ecosistema colaborativo de referencia en el ámbito biosanitario con la celebración de su 8ª sesión de trabajo, un encuentro que ha permitido evaluar…
Ver más →
MeetUp: ¿Cómo vender a un hospital?

Regulatory Thursdays 12:30-2pm

Bio-all PTS I Sparkathon: Innovación en Salud.

Jornada de Transferencia Hospital-Empresa-Universidad
Omologic hace visible a medio centenar de fabricantes españoles con productos seguros frente a COVID-19

Ciclo de Ciberseguridad

Jornada de cooperación empresarial en el ámbito de la Salud
